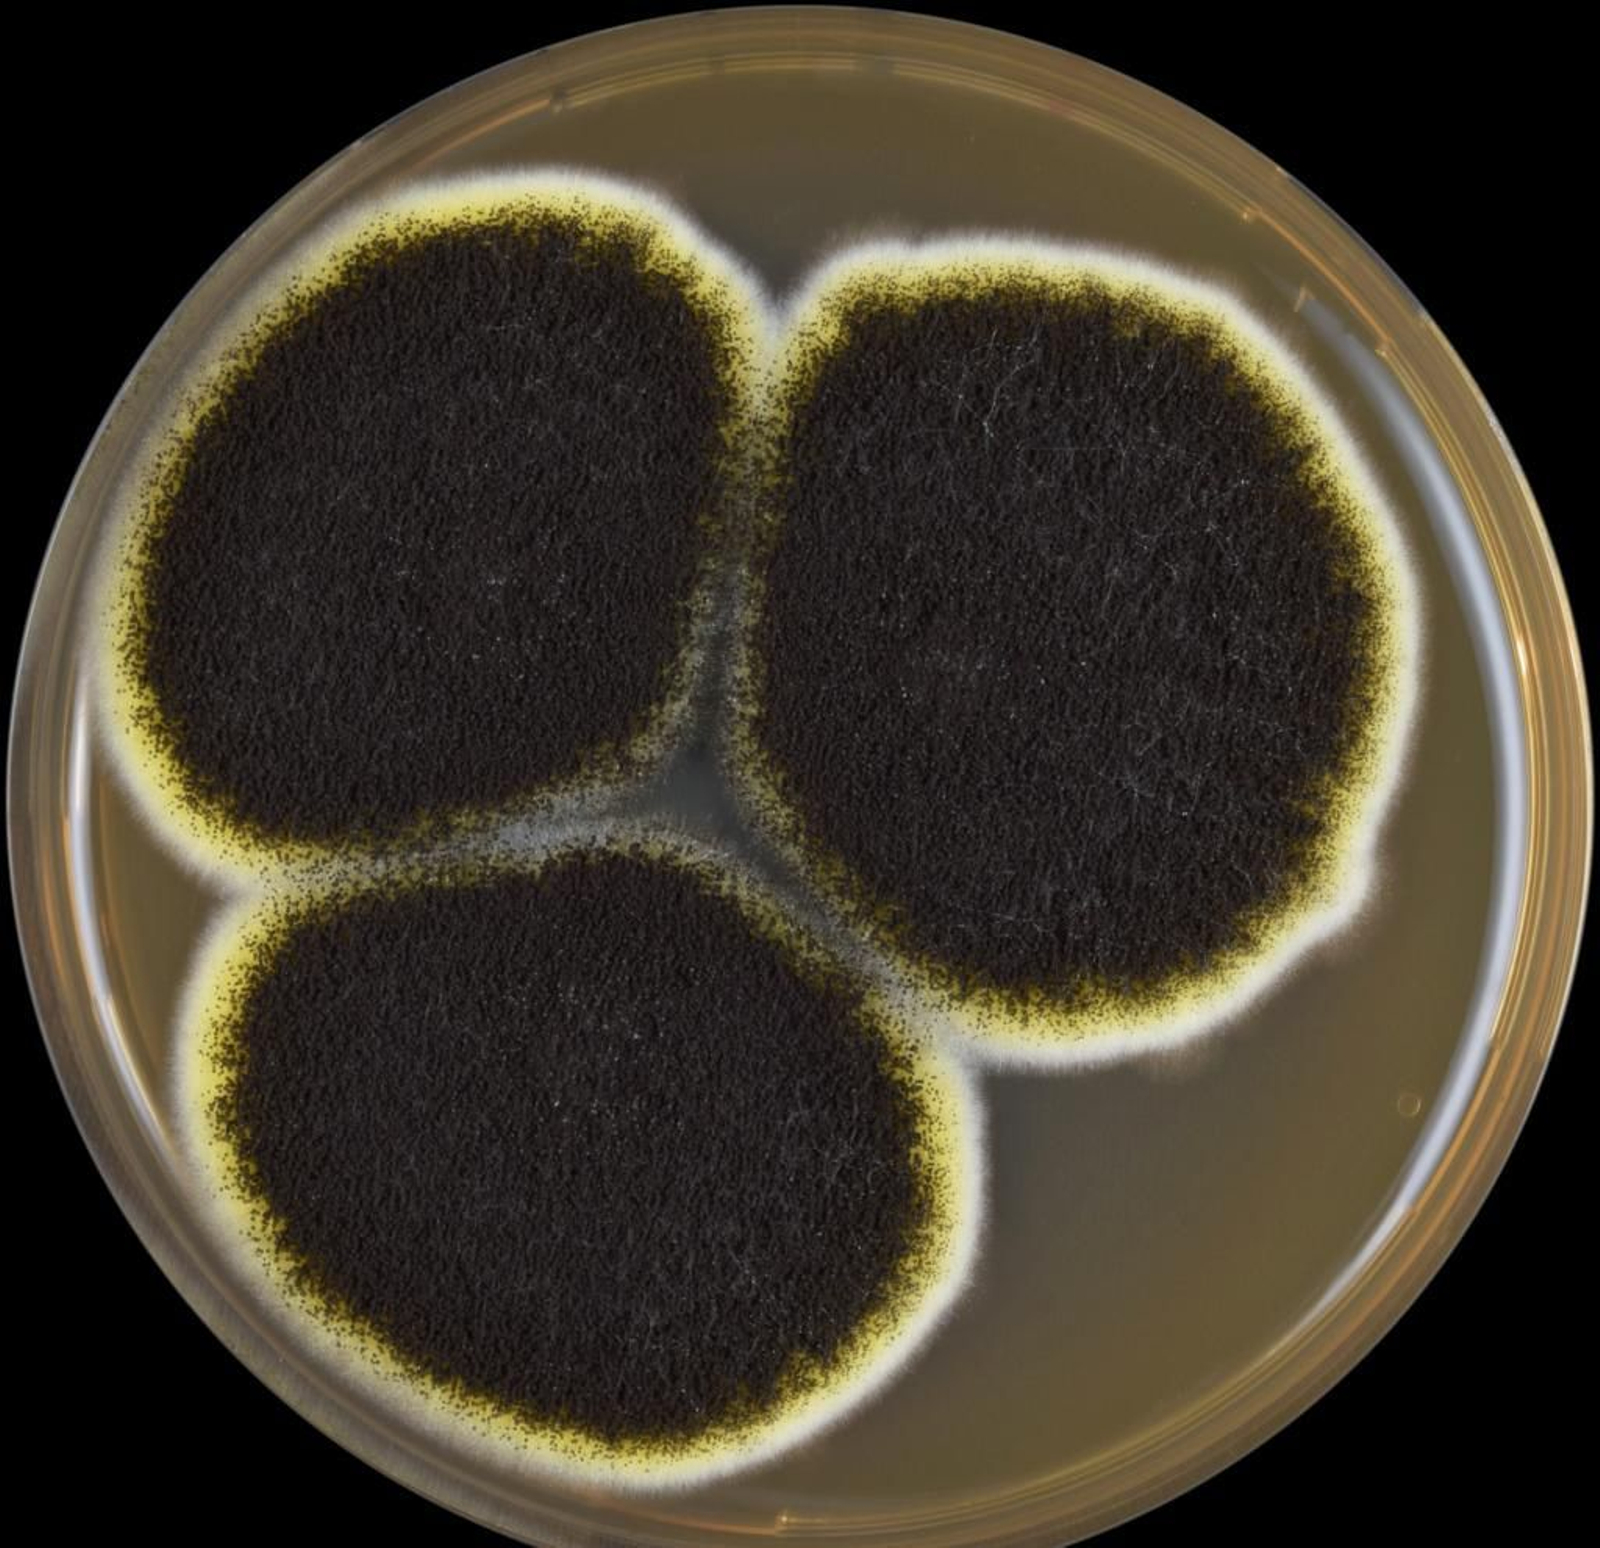
Aspergillus niger meaox.

Biotecnología: No nos olvidemos, pensemos en los hongos
Ciencia Abierta
Tres casos de investigaciones biotecnológicas que usan a los hongos para aplicaciones sorprendentes
Biotecnología: me importan, y mucho, los pimientos

Continuamos difundiendo en Ciencia Abierta las potencialidades que nos ofrece la Biotecnología como disciplina investigadora de primer nivel y las enormes posibilidades que nos abre para mejorar nuestras vidas en campos en ocasiones insospechados. ¿Podríamos pensar en los hongos, ese reino de seres vivos tan poco conocido, como una herramienta biotecnológica para desintoxicar cuando quizás lo primero que pensamos es que los hongos, en algunos casos, son tóxicos para el ser humano o que puedan estar junto a residuos radiactivos? Mostremos tres ejemplos de investigaciones de estudiantes del master de Biotecnología de la Universidad de Granada que nos convencerán del potencial benéfico de estos maltratados seres vivos.
En la Estación Experimental del Zaidín (CSIC), en colaboración con la empresa MAFA-BioScience, ha trabajado María Camila Espinosa Araque para dar respuesta al desafío ambiental que supone el residuo tóxico llamado alperujo (o alpeorujo). El alperujo es un residuo generado durante la producción del aceite de oliva que contiene gran cantidad de materia orgánica con contenido en compuestos fenólicos tóxicos. ¿Se pueden reducir esos compuestos tóxicos e incluso aprovechar ese residuo para fines agrícolas? Los hongos nos dicen que sí. Mediante el uso de hongos saprobios que tienen la capacidad de utilizar la materia orgánica en descomposición como su principal alimento y transformarla en otros compuestos con capacidad de uso como biofertilizantes en agricultura. La biotransformación del alperujo por parte de hongos de los géneros Penicillium, Fusarium, Pycnoporus y Bjerkandera, seleccionados previamente entre casi un centenar de hongos, permitió reducir su contenido fenólico en casi un 50%. Y en una segunda parte, se realizó un ensayo en invernadero utilizando plantas de trigo para evaluar el impacto de estos productos de biotransformación del alperujo en el crecimiento y fisiología de las plantas de trigo, así como en la salud del suelo. Se encontró que los hongos empleados no solo desintoxicaron el extracto líquido de alpeorujo al reducir su contenido fenólico, además se observó una notable estimulación del crecimiento en las plantas de trigo suplementadas con el alperujo desintoxicado, en particular destacar el efecto biofertilizante del extracto de alpeorujo biotransformado por las cepas Bjerkandera y Pycnoporus. Por tanto estos trabajos representan un paso significativo hacia la promoción de prácticas agrícolas sostenibles, aprovechando recursos existentes para impulsar la productividad de manera respetuosa con el medio ambiente.
El trabajo con estos residuos vegetales puede que les resulten no muy extraños, pero los hongos son organismos ubicuos, están en todas partes, y no solo en las formas más conocidas. Ya saben compramos níscalos sabrosos y deliciosos en el mercado o hacemos cremas de champiñones, al máximo entendemos que gracias a ciertos hongos microscópicos, las levaduras, tenemos muchas aplicaciones en la alimentación, desde el pan a la cerveza y otras muchas que la humanidad aprovecha desde hace milenios. Pero, aún hay más…si las condiciones no son adecuadas para el hongo, sus esporas pueden resistir mucho y mucho tiempo.
Esto sucede en el Almacenamiento Geológico Profundo (AGP). El AGP es una técnica utilizada para la gestión a largo plazo de los residuos radiactivos de alta actividad producidos por las centrales nucleares, combinando una serie de barreras para el aislamiento de estos radionucléidos. Estos están en un recipiente metálico el cual está rodeado de un tipo de arcilla previamente tratada: la bentonita. La bentonita presenta una composición mineralógica y estructural que la hace idónea para proporcionar protección al contenedor metálico y reducir la migración de los residuos radiactivos a la biosfera. Dado que se trata de un material poroso, diferentes seres vivos ubicuos pueden establecerse en el interior de la bentonita, lo cual puede comprometer el correcto desarrollo de sus funciones. Lidia López-Tercero García-Cano, con el equipo de investigación del Departamento de Microbiología de la Facultad de Ciencias de la UGR, ha tratado este tema sometiendo a la bentonita a distintos tratamientos que dificultan el establecimiento de los microorganismos, disminuyendo su biodiversidad y abundancia. Aun así, muchos de estos resisten y debido a que se sabe más sobre la biodiversidad bacteriana de la bentonita, se ha desarrollado un estudio enfocado en la biodiversidad fúngica. Se aislaron hongos de bentonitas sometidas a diferentes condiciones, como compactación o elevadas temperaturas. Los resultados revelaron la presencia de algunos hongos a la mayoría de tratamientos, como algunas especies del genero Aspergillus, en concreto Aspergillus niger. Se ha puesto de manifiesto que esos hongos tienen actividades metabólicas que podrían estar implicadas en la alteración de la bentonita, resultando muy relevante su elevada producción de ácidos orgánicos. El estudio llevado a cabo no sólo avisa de un potencial riesgo, sino que en lo positivo facilita avances en investigación para evaluar la viabilidad de los hongos productores de ácidos orgánicos usando materiales tan insospechados como esas arcillas.
No dejemos de sorprendernos y démonos cuenta de la importancia de conocer lo que nos rodea, de conocer la biodiversidad de seres vivos. En ello trabaja Laura Mercedes Sánchez Giraldo, aquí y en Colombia. Su proyecto inicial trata de buscar respuesta al reto que supone enfrentarse a nuevas enfermedades o a la resistencia bacteriana a fármacos tradicionales. ¿Podemos encontrar nuevos metabolitos de interés farmacéutico entre los hongos? Dado que su país natal es el segundo con mayor biodiversidad del mundo, el estudio de la micología o micetología (ciencia que estudia los hongos, aunque pueda parecer otra cosa) tiene gran auge y hay numerosos estudios para avanzar en el conocimiento de sus especies y la biodiversidad fúngica a varios niveles. Desde la bioprospección y la etnomicología se estudian los usos tradicionales de los hongos por diversas comunidades de población que los han usado como alimentos medicinales en algunos casos y que han transmitido su uso de generación en generación. Y desde la biotecnología más avanzada se buscan cepas de hongos que produzcan sustancias no conocidas hasta ahora y que tengan un potencial valor biomédico. Así en sus trabajos con técnicas de HPLC e identificación molecular pudo encontrar cepas fúngicas con capacidad de producir nuevos productos. Ello no hubiera sido posible sin reconocer la importancia que tiene estudiar la biodiversidad de esos, a menudo ignorados, seres del reino de los Hongos. Y con las herramientas que dispone la biotecnología seguiremos teniendo más sorpresas.
También te puede interesar








